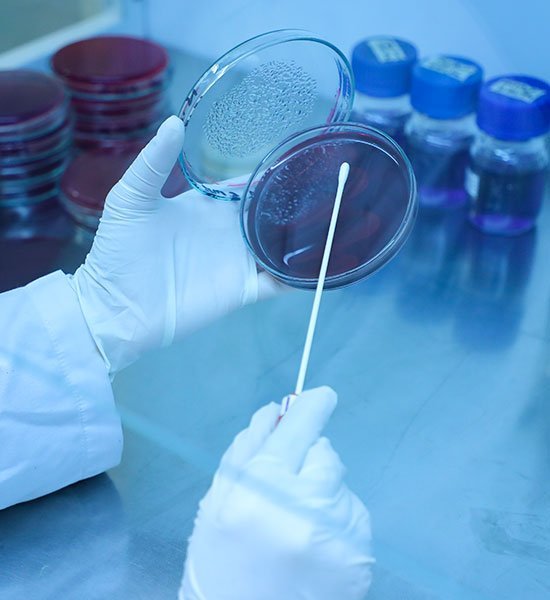

Scilife Pharma Manufacturing Facility has been designed and built as per local and international regulatory requirements. Manufacturing Operations are meeting the cGMP standards in order to deliver high quality pharmaceutical products that ensure product quality, safety and efficacy
The Quality and Compliance team comprises of experienced professionals, which has successfully established Quality Policy, Quality Manuals, Laboratory Information File, SOP’s in compliance with local/international regulatory requirements.
Scilife Pharma has implemented an effective Pharmaceutical Quality System (PQS) that is adequately resourced, with defined roles, responsibilities, effectively communicated and implemented throughout the Organization.
The Scilife Manufacturing Facility has achieved the following ISO certifications:
-
ISO 9001:2015 for Quality Management System
-
ISO 14001:2015 for Environment Management System
-
ISO 45001:2018 for Occupational Health Safety Management System
-
Pakistan National Accreditation Council (PNAC) certification 17025
The manufacturing Operations are geared for maximum efficiencies by following defined protocols and SOP’s.
The whole process is abetted and supported by Quality Assurance, which ensures the end-products Quality, safety and efficacy as per specifications.